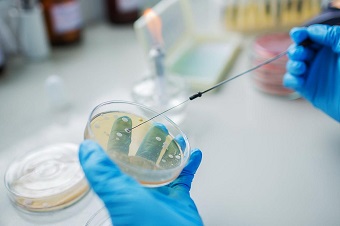
Бактериологическое исследование отделяемого из уха

КТ, МРТ при коалесцентном отомастоидите и его осложнениях
Добавил пользователь Алексей Ф. Обновлено: 16.01.2026
а) Терминология:
1. Аббревиатуры:
• Острый коалесцентный отомастоидит (ОКОМ)
• Острый отомастоидит (ООМ)
2. Синоним:
• Коалесцентный отомастоидит с абсцессом
3. Определения:
• ОКОМ: острая инфекция среднего уха и сосцевидного отростка (СУ-СО) с прогрессирующей резорбцией кости и деминерализацией вследствие интрамастоидальной эмпиемы ± остеомиелита
• ОКОМ + абсцесс: коалесцентный отомастоидит с результирующим интра- или экстракраниальным абсцессом
• ООМ: острая инфекция СУ-СО без деструкции перегородок сосцевидного отростка и кортикальной пластинки
б) Визуализация:
1. Общая характеристика:
• Лучший диагностический критерий:
о Скопление жидкости (с накоплением контраста в виде «кольца»), эрозия прилежащих отделов кортикального слоя сосцевидного отростка + снижение пневматизации ячеек сосцевидного отростка
• Локализация:
о Абсцесс рядом с нарушенным кортикальным слоем сосцевидного отростка:
- Наружная стенка сосцевидного отростка:
Заушный (тонкая кортикальная пластинка) абсцесс
Пред- или околоушный абсцесс
- Нижняя стенка сосцевидного отростка:
Вершина → абсцесс Бецольда
Разрушение кортикальной пластинки сосцевидного отростка в других отделах → абсцесс смежных тканей
- Крыша сосцевидной пещеры - абсцесс височной доли
- Внутренняя стенка сосцевидного отростка → эпидуральный абсцесс задней черепной ямки, мозжечка
• Размер:
о Варьирует; обычно >1 см
• Морфология:
о Серповидная, чечевицеобразная, сферическая

(Слева) При аксиальной МРТ Т2 ВИ FS у девочки 15 лет с болезненностью с области сосцевидного отростка и головной болью визуализируется гиперинтенсивный эпидуральный абсцесс возле кортикального слоя сосцевидного отростка, гипоинтенсивный тромб в сигмовидном синусе и абсцесс мозжечка, окруженный гипоинтенсивным «ободком» и зоной отека. В прилежащих ячейках сосцевидною отростка определяется жидкость.
(Справа) При аксиальной MPT Т1 ВИ С+ у этого же пациента визуализируется эпидуральный абсцесс, тромб в сигмовидном синусе и абсцесс мозжечка - гипоинтенсивные с периферическим накоплением контраста.
2. КТ при коалесцентном отомастоидите и его осложнениях:
• КТ с КУ:
о Поднадкостничный абсцесс: скопление жидкости возле ушной раковины:
- Утолщение и контрастное усиление наружной стенки отражает воспаление надкостницы
о Абсцесс Бецольда: отграниченное скопление гноя в грудино-ключично-сосцевидной мышце или рядом с ней
о Абсцесс средней черепной ямки:
- Эпидуральное (или в височной доле) скопление жидкости (с контрастированием в виде «кольца»)
о Абсцесс задней черепной ямки:
- Жидкость (эпидурально/в мозжечке) с контрастированием в виде «кольца»
• Костная КТ:
о Снижение пневматизации СУ-СО
о Вариабельные эрозии трабекул и кортикального слоя (КТ признак сливного отомастоидита)
о Минимальная или значительная деструкция кортикального слоя сразу же под абсцессом:
- Наружный кортекс сосцевидного отростка - поднадкостничный абсцесс
- Кортикальный слой вершины сосцевидного отростка → абсцесс Бецольда
- Крыша сосцевидной пещеры → эпидуральный абсцесс или абсцесс височной доли
- Медиальный кортикальный слой сосцевидного отростка — эпидуральный или мозжечковый абсцесс
• КТВ:
о Возможен тромбоз сигмовидного синуса и/или внутренней яремной вены (ВЯВ)
3. МРТ при коалесцентном отомастоидите и его осложнениях:
• Т2 ВИ FS:
о Гиперинтенсивный сигнал в СУ-СО
о Гиперинтенсивный сигнал в эпидуральном или паренхиматозном абсцессе
о Гипоинтенсивный сигнал в сигмовидном или в ВЯВ при наличии тромбов
• ДВИ:
о Снижение диффузии в абсцессе
• Т1 ВИ С+ FS:
о Вариабельное контрастирование СУ-СО
о Гной (с КУ в виде «кольца»): поднадкостничный, интракраниальный (эпидуральный или паренхиматозный) абсцесс
о Дефект(ы) наполнения в сигмовидном синусе и/или ВЯВ (тромбы)
• МРВ:
о Возможен тромбоз дуральных синусов/вен (ТДС/ТДВ)
4. Рекомендации по визуализации:
• Лучший метод визуализации:
о КТ височных костей: слияние ячеек, деструкция кортикального слоя:
- КТ с КУ: выявление большинства инфекционных осложнений
о МРТ височных костей С+: выше чувствительность для интракраниальных осложнений (ТДС, менингит, субдуральная эмпиема, паренхиматозный абсцесс)
• Выбор протокола:
о МРТ С+: малая толщина срезов (

(Слева) При корональной МРТ Т1 ВИ С+ FS у этого же пациента ниже тромбированного сигмовидного синуса визуализируется эллипсовидный эпидуральный абсцесс. Виден и абсцесс в мозжечке; намет мозжечка накапливает контраст.
(Справа) При аксиальной КТ височной кости у этот же пациента определяется снижение пневматизации среднего уха и ячеек сосцевидного отростка, наряду с эрозией кортикального слоя сосцевидного отростка (сзади) и слуховых косточек, сопоставимой с отомастоидитом и холестеатомой, что и было подтверждено при операции.
в) Дифференциальная диагностика коалесцентного отомастоидита и его осложнений:
1. Приобретенная холестеатома:
• Клиническая картина: втяжение или разрыв барабанной перепонки; возможна суперинфекция
• Визуализация: объемное образование с эрозиями (КТ); неконтрастирующееся образование со снижением диффузии (МРТ)
• В сочетании с ОКОМ может приводить к экстра- или интракраниальному абсцессу
2. Апикальный петрозит:
• Клиническая картина: парез ЧН VII, боль за ухом, ООМ
• Визуализация: коалесценция пневматизированной вершины пирамиды:
о МРТ Т1 ВИ С+: контрастное усиление оболочек мозга и отграниченное скопление жидкости в вершине пирамиды
• У молодых пациентов редко может обнаруживаться остеомиелит непневматизированной вершины пирамиды → контрастирование костного мозга на Т1 ВИ С+ FS, сужение каменистого сегмента внутренней сонной артерии
3. Лангергансоклеточный гистиоцитоз височной кости:
• Клиническая картина: ребенок с отореей и объемным образованием за ухом
• Визуализация: распространенная, иногда двухсторонняя деструкция сосцевидного отростка объемным образованием, накапливающим контраст
4. Рабдомиосаркома височной кости:
• Клиническая картина: типичен неврологический дефицит, включая паралич ЧН VII
• Визуализация: литическая деструкция костей (КТ); интракраниальное распространение:
о МРТТ1 ВИ С+: контрастирующееся мягкотканное образование
5. Метастазы в височной кости:
• Клиническая картина: оторея, оталгия, опухоль около ушной раковины
• Визуализация: литическая деструкция костей ± объемное образование
г) Патология:
1. Общая характеристика:
• Этиология:
о Блокада входа в пещеру с нарушением дренирования ячеек из-за воспаления, грануляционной ткани, холестеатомы
о Резорбция трабекул ферментами (сливной отомастоидит) из-за местной гиперемии и ацидоза
о Легкая или выраженная деструкция кортикального слоя с распространением инфекции в соседние ткани
о Наименее типичная патофозиология: интактный кортикальный слой сосцевидного отростка с септическим тромбофлебитом эмиссарных вен и поражением надкостницы
• Треугольник Макюэна:
о Оперативный доступ к сосцевидной пещере: задне-верхние отделы ИСК
о Ослабление кости, разрыхление периоста способствует распространению инфекции в заушную область
2. Макроскопические и хирургические особенности:
• Гной в сосцевидном отростке, остеомиелит, полость абсцесса поблизости
• Грануляционная ткань или холестеатома крайне редко обнаруживаются в СУ-СО:
о Чаще при подостром и хроническом заболевании
о Требуют более обширного вмешательства
3. Микроскопия:
• Полимикробная аэробная и анаэробная инфекция
• Часто - стрептококки
д) Клинические особенности:
1. Проявления:
• Типичные признаки/симптомы:
о Оталгия (боль в ухе) ± оторея (выделения из уха)
о Боль за ухом + отек
о Лихорадка
о Другие признаки/симптомы со стороны височных костей:
- Латерализация ушной раковины (смещение уха кнаружи абсцессом)
- Тугоухость: кондуктивная » нейросенсорная
о Интракраниальные осложнения
- Головная боль, нарушение психического состояния, тошнота, рвота, судороги
- Ригидность затылочных мышц и фотофобия
- Отек диска зрительного нерва
- Паралич ЧНVI
• Клинический профиль:
о Ребенок с оталгией, отеком заушных тканей, лихорадкой, отореей длительностью от нескольких дней до месяцев
о 35-70% пациентов уже получали антибиотики по поводу ООМ
о Отек заушных тканей (симптом Гризингера) типичен для неосложненного острого отомастоидита (85%):
- Чтобы подтвердить поднадкостничный абсцесс, необходимо обнаружить скопление жидкости, накапливающее контраст
2. Демография:
• Возраст:
о Младенцы и младшие дети
о Если является осложнением приобретенной холестеатомы, часто поражается более старшая возрастная группа
• Эпидемиология:
о ОКОМ возникает у 0,24% пациентов с ООМ
3. Течение и прогноз:
• Изолированный экстракраниальный поднадкостничный абсцесс:
о Прогноз при адекватном лечении великолепный
о Хуже при незавершенной антибиотикотерапии (ранее), вирулентном возбудителе, иммунодефиците у хозяина
• Интракраниальный абсцесс (чаще всего височной доли):
о Прогноз хуже
о При сопутствующих осложнениях прогноз еще хуже:
- Тромбоз венозного синуса
- Эпидуральный абсцесс или субдуральная эмпиема
4. Лечение:
• Антибиотики внутривенно ±тимпаноцентез, миринготомия и дренирование
• Хирургическое лечение:
о Иссечение и дренирование экстракраниального поднадкостничного абсцесса ± мастоидэктомия с сохранением стенки слухового канала
• Хирургическое лечение должно осуществляться с целью сохранения слуха:
о Мастоидэктомия с удалением стенки канала при холестеатоме
е) Диагностическая памятка:
1. Следует учесть:
• Другие осложнения ОКОМ:
о Изменения височной кости (MPT: Т1 ВИ С+):
- Паралич лицевого нерва: контрастное усиление ЧН VII
- Лабиринтит: контрастирование перепончатого лабиринта
- Апикальный петрозит (контрастирование апикальных ячеек при МРТ)
о Интракраниальные изменения (MPT: Т1 ВИ С+):
- Субдуральная эмпиема, менингит, абсцесс мозга ± тромбоз дуральных синусов или ВЯВ
2. Советы по интерпретации изображений:
• МРТ позволяет отличить гиперинтенсивный перисинусный эпидуральный абсцесс от гипоинтенсивного ТДС
• Эпидуральный абсцесс эллиптический; ТДС округлый/треуголь-ный
КТ, МРТ при коалесцентном отомастоидите и его осложнениях
1. Аббревиатура:
• Хронический отомастоидит (ХОМ)
2. Синонимы:
• Нехолестеатоматозная эрозия слуховых косточек; поствоспалительная эрозия слуховых косточек
3. Определение:
• Эрозия слуховых косточек в отсутствие холестеатомы у пациента с ХОМ
б) Визуализация:
• Костная КТ:
о Необходимо оценить анатомию слуховых косточек:
- Аксиальная КТ/эпитимпанум: «мороженое в рожке» (передняя часть или «мороженое» = головка молоточка; задняя часть или «рожок»=тело наковальни/короткий отросток)
- Аксиальная КТ/мезотимпанум: «две параллельные линии» [передняя линия = сухожилие мышцы, напрягающей барабанную перепонку, идущее к шейке молоточка; задняя линия = лентикулярный отросток наковальни, наковальне-стременной сустав (НСС) и головка стремечка]
- Корональная КТ на уровне длинного отростка наковальни: «прямой угол» (вертикально ориентированный длинный отросток наковальни, горизонтально ориентированный лентикулярный отросток)
о Аксиальная КТ в костном окне:
- Частичное отсутствие одной из «двух параллельных линий» (задней)
о НСС может быть замещен фиброзной тканью:
На аксиальной КТ НСС выглядит расширенным
- Также возникают эрозии «рожка» (тело/короткий отросток наковальни)
о Корональная КТ в костном окне:
- Длинный отросток наковальни чаще всего отсутствует:
Вертикальный сегмент «прямого угла» отсутствует
- Часто обнаруживается втяжение барабанной перепонки
о Типично снижение пневматизации сосцевидного отростка

(Слева) На рисунке (поперечный срез) левой височной кости показаны поствоспалительные эрозии длинного отростка наковальни и основания стремечка. Обратите внимание на склероз барабанной перепонки и слуховых косточек.
(Справа) При корональной КТ в костном окне определяется втяжение утолщенной барабанной перегородки наряду с деминерализацией длинного отростка наковальни. Уплотненные мягкие ткани в среднем ухе обусловлены сопутствующим воспалительным дебрисом.
в) Дифференциальная диагностика хронического отомастоидита с эрозиями слуховых косточек:
1. Легкая врожденная мальформация наружного уха:
• Врожденная тугоухость; микротия
• КТ: ротация ± слияние слуховых косточек
2. Приобретенная холестеатома + эрозии слуховых косточек:
• КТ: сопутствующее мягкотканное объемное образование о Перфорация или втяжение барабанной перегородки
3. Врожденная холестеатома среднего уха + эрозии слуховых косточек:
• КТ: мягкотканный компонент обычно изнутри от слуховых косточек
• Сопутствующие фокальные эрозии слуховых косточек
4. Отсутствие слуховых косточек (постоперационные изменения):
• Признаки мастоидэктомии/аттикотомии
• КТ: чаще всего стапедэктомия по поводу отосклероза
5. Посттравматическое смещение слуховых косточек:
• Сломанные, смещенные слуховые косточки могут выглядеть отсутствующими

(Слева) При аксиальной КТ в костном окне визуализируется нормальный короткий отросток наковальни справа и головка молоточка. Обратите внимание на хорошо пневматизированный сосцевидный отросток.
(Справа) При аксиальной КТ левой височной кости у пациента с хроническим средним отитом в анамнезе определяется деоссификация короткого отростка наковальни слева. Головка молоточка по размерам и плотности не изменена. Пневматизация сосцевидного отростка снижена вследствие отомастоидита во время его формирования.
г) Патология. Общая характеристика:
• Этиология:
о ХОМ инициирует резорбцию слуховых косточек
о Начальная стадия: периостит и остеит
о Потеря костной ткани в результате остеоклазии и декальцификации
о Наковальня наиболее уязвима вследствие слабого кровоснабжения
1. Проявления:
• Типичные признаки/симптомы:
о Поствоспалительная кондуктивная тугоухость:
- Часто: длительная история хронического среднего отита
2. Демография:
• Эпидемиология:
о Очень частое заболевание, обнаруживаемое клинически и при КТ
3. Течение и прогноз:
• Хирургическое лечение дает различные результаты
• В зависимости от выраженности разрушения слуховых косточек и состояния БП:
о Поражение молоточка - важный предиктор состояния слуха после операции, вне зависимости от поражения стремечка
4. Лечение:
• Ревизионная тимпанотомия и реконструкция слуховых косточек
1. Следует учесть:
• У пациентов с кондуктивной тугоухостью:
о Оцените резорбцию слуховых косточек на фоне ХОМ
о Затем рассмотрите другие заболевания:
- Фенестральный отосклероз
- Врожденная мальформация слуховых косточек (при легкой мальформации ИСК)
2. Советы по интерпретации изображений:
• Отсутствие сегмента в цепи слуховых косточек:
о Частая находка при КТ; легко просматривается
ж) Список использованной литературы:
1. Albera R et al: Ossicular chain lesions in tympanic perforations and chronic otitis media without cholesteatoma. J Int Adv Otol. 11 (2): 143-6, 2015
2. Blom EF et al: Influence of ossicular chain damage on hearing after chronic otitis media and cholesteatoma surgery: a systematic review and metaanalysis. JAMA Otolaryngol Head Neck Surg. 1-9, 2015
3. Swartz JD et al: Ossicular erosions in the dry ear: CT diagnosis. Radiology. 163(3):763-5, 1987
1. Аббревиатура:
• Хронический отомастоидит (ХОМ) с тимпаноскперозом
2. Синонимы:
• ХОМ с фокальными кальцинатами или оссификатами
• Поствоспалительная фиксация слуховых косточек
3. Определение:
• Кальцинаты, костные или фиброзные очаги в среднем ухе вследствие гнойного ХОМ
б) Визуализация:
• Лучший диагностический критерий:
о КТ в костном окне: плотные очаги в среднем ухе и сосцевидном отростке (СУ-СО) в сочетании со спорадическим воспалительным дебрисом

(Слева) На рисунке (поперечный срез) показан тяжелый тимпаносклероз в условиях хронического отомастоидита. Поствоспалительные обызвествления могут обнаруживаться в барабанной перепонке, слуховых косточках и их связках.
(Справа) При корональной КТ височной кости визуализируются слуховые косточки, объединенные в неправильный шар. Эти изменения обусловлены отложением извести на поверхности слуховых косточек при тимпаносклерозе.
1. КТ при хроническом отомастоидите с тимпаносклерозом:
• КТ в костном окне:
о Типичная локализация Са++ при тимпаноскперозе:
- Барабанная перепонка
- Поверхность слуховых косточек
- Основание стремечка:
Утолщение ножек и основания
Рассматривается какоколостременной фиброз
- Сухожилия мышц:
Стременной; мышцы, напрягающей барабанную перепонку
- Связки слуховых косточек
- Ячейки сосцевидного отростка
о Фокальные тимпаносклеротические оссификаты:
- Скопления вновь образованной костной ткани (остеонеогенез)
- Могут возникать в любых отделах СУ-СО
о Признаки хронического отомастоидита:
- Неоднородный мягкотканный компонент (воспалительный) в СУ-СО
- Снижение пневматизации сосцевидного отростка

(Слева) При аксиальной КТ в костном окне определяется локальный участок оссифицирующего тимпаносклероза сразу же за слуховыми косточками в медиальной стенке эпитимпанум. Также обратите внимание на слияние наковальне-молоточкового сустава. В сосцевидном отростке присутствует лишь сосцевидная пещера.
(Справа) При корональной КТ в костном окне определяется утолщение барабанной перепонки с вытянутым кальцинатом вдоль ее поверхности. Обызвествления при тимпаносклерозе могут обнаруживаться в связках, сухожилиях, слуховых косточках, или в барабанной перепонке, как в этом случае.
в) Дифференциальная диагностика хронического отомастоидита с тимпаносклерозом:
1. Хронический средний отит:
• Клинические проявления: кондуктивная тугоухость (КТУ) различной выраженности:
о ХОМ в анамнезе
• КТ: неоднородный, недеструктивный дебрис в среднем ухе:
о Дебрис не содержит кальцинатов или оссификатов
2. ХОМ с эрозиями слуховых косточек:
• Клинические проявления: ХОМ + КТУ
• КТ: воспалительный дебрис, разрушение слуховых косточек
3. ХОМ с фиксацией слуховых косточек:
• Клинические проявления: ХОМ + КТУ
• КТ: фокальный анкилоз
о Может присутствовать тимпаносклеротический компонент
4. Фенестральный отосклероз:
• Клинические проявления: без ХОМ в анамнезе (сосцевидный отросток хорошо пневматизирован)
• КТ: просветление в области щели перед овальным окном:
о В сочетании со склерозом улитки
1. Общая характеристика:
• Этиология:
о Ответ на повторяющиеся эпизоды воспаления
о Истинный кальцинирующий тимпаноскпероз:
- Диффузная гиалинизация с накоплением кальция и кристаллов фосфатов
о Оссифицирующийтимпаносклероз:
- Образование новой костной ткани (остеонеогенез)
• Сопутствующие патологические изменения:
о Слияние волокон коллагена:
- Уплотнение волокон при отложении в них кальция и кристаллов фосфатов
2. Стадирование, классификация хронического отомастоидита с тимпаносклерозом:
• Три типа поствоспалительной фиксации слуховых косточек:
о Фиксация фиброзной тканью:
- Нет кальцинатов
- Может возникать в любых отделах СУ-СО
о Истинный кальцинирующий тимпаноскпероз:
- Множественные мелкие кальцинаты
о Оссифицирующий тимпаноскпероз:
- Формирование новой кости (остеонеогенез)
3. Микроскопия:
• Обызвествление ранее гиалинизованного мукопериоста
• Слоистые напластования в виде «луковой чешуи»
г) Клинические особенности:
1. Проявления:
• Типичные признаки/симптомы:
о Тяжелая КТУ + ХОМ в анамнезе
• Другие признаки/симптомы:
о Отоскопия: утолщение и снижение прозрачности барабанной перепонки
2. Демография:
• Возраст:
о Средний возраст на момент диагностики = 35 лет
• Эпидемиология:
о Тимпаноскпероз возникает у 10% пациентов с гнойным ХОМ
3. Лечение:
• Аттикотомия с мобилизацией слуховых косточек:
о У пациентов с менее выраженным поражением слуховых косточек лучше сохраняется слух после операции
• Протезирование или установка гомографта
д) Диагностическая памятка. Следует учесть:
• При КТУ у пациентов с ХОМ вначале предполагайте фенестральный отосклероз
е) Список использованной литературы:
1. Mutlu F et al: An analysis of surgical treatment results of patients with tympanosclerosis. J Craniofac Surg. 26(8):2393-5, 2015
2. Stankovic MD: Hearing results of surgery for tympanosclerosis. Eur Arch Otorhinolaryngol. 266(5):635-40, 2009
3. Swartz JD et al: Postinflammatory ossicular fixation: CT analysis with surgical correlation. Radiology. 154(3):697-700, 1985
Мастоидит
Мастоидит — воспалительное поражение сосцевидного отростка височной кости инфекционного генеза. Чаще всего мастоидит осложняет течение острого среднего отита. Клинические проявления мастоидита включают подъем температуры тела, интоксикацию, боли и пульсацию в области сосцевидного отростка, отечность и гиперемию заушной области, боль в ухе и снижение слуха. Объективное обследование при мастоидите заключается в осмотре и пальпации заушной области, отоскопии, аудиометрии, рентгенографии и КТ черепа, бактериологическом посеве отделяемого из уха. Лечение мастоидита может быть медикаментозным и хирургическим. В его основе лежит антибиотикотерапия и санация гнойных очагов в барабанной полости и сосцевидном отростке.
МКБ-10



Общие сведения
Сосцевидный отросток представляет собой выступ височной кости черепа, расположенный позади ушной раковины. Внутренняя структура отростка сформирована сообщающимися ячейками, которые разделены между собой тонкими костными перегородками. У разных людей сосцевидный отросток может иметь различное строение. В одних случаях он представлен крупными заполненными воздухом ячейками (пневматическое строение), в других случаях ячейки мелкие и заполнены костным мозгом (диплоэтическое строение), в третьих — ячеек практически нет (склеротическое строение). От типа строения сосцевидного отростка зависит течение мастоидита. Наиболее склонны к появлению мастоидита лица с пневматическим строением сосцевидного отростка.
Внутренние стенки сосцевидного отростка отделяют его от задней и средней черепных ямок, а специальное отверстие сообщает его с барабанной полостью. Большинство случаев мастоидита возникает как следствие перехода инфекции из барабанной полости в сосцевидный отросток, что наблюдается при остром среднем отите, в отдельных случаях при хроническом гнойном среднем отите.

Причины мастоидита
В зависимости от причины возникновения в отоларингологии различают отогенный, гематогенный и травматический мастоидит.
- Отогенный. Наиболее часто возникает вторичный мастоидит, обусловленный распространением инфекции в сосцевидный отросток из барабанной полости среднего уха. Его возбудителями могут быть палочка инфлюэнцы, пневмококки, стрептококки, стафилококки и др. Переходу инфекции из полости среднего уха способствует нарушение ее дренирования при позднем прободении барабанной перепонки, несвоевременном проведении парацентеза, слишком малом отверстии в барабанной перепонке или его закрытии грануляционной тканью.
- Гематогенный. В редких случаях наблюдается мастоидит, развившийся в следствие гематогенного проникновения инфекции при сепсисе, вторичном сифилисе, туберкулезе.
- Травматический. Первичный мастоидит возникает при травматических повреждениях ячеек сосцевидного отростка вследствие удара, огнестрельного ранения, черепно-мозговой травмы. Благоприятной средой для развития патогенных микроорганизмов в таких случаях является кровь, излившаяся в ячейки отростка в результате травмы.
Появлению мастоидита способствует:
- повышенная вирулентность патогенных микроорганизмов
- ослабленное состояние общего при хронических заболеваниях (сахарный диабет, туберкулез, бронхит, гепатит, пиелонефрит, ревматоидный артрит и пр.)
- патология носоглотки (хронический ринит, фарингит, ларинготрахеит, синусит)
- наличие изменений в структурах уха в связи с перенесенными ранее заболеваниями (травмы уха, аэроотит, наружный отит, адгезивный средний отит).
Патогенез
Начало мастоидита характеризуется воспалительными изменениями слизистого слоя ячеек сосцевидного отростка с развитием периостита и скоплением жидкости в полостях ячеек. Из-за выраженной экссудации эта стадия мастоидита получила название экссудативной. Воспалительная отечность слизистой приводит к закрытию отверстий, сообщающих ячейки между собой, а также отверстия, соединяющего сосцевидный отросток с барабанной полостью. В результате нарушения вентиляции в ячейках сосцевидного отростка, в них падает давление воздуха. По градиенту давлений в ячейки начинает поступать транссудат из расширенных кровеносных сосудов. Ячейки заполняются серозным, а затем серозно-гнойным экссудатом. Длительность первой стадии мастоидита у взрослых составляет 7-10 дней, у детей чаще 4-6 дней. В конечном итоге экссудативной стадии мастоидита каждая ячейка имеет вид эмпиемы — заполненной гноем полости.
Далее мастоидит переходит во вторую стадию — пролиферативно-альтеративную, в которой гнойное воспаление распространяется на костные стенки и перегородки сосцевидного отростка с развитием остеомиелита — гнойного расплавления кости. Одновременно с этим происходит образование грануляционной ткани. Постепенно перегородки между ячейками разрушаются и формируется одна большая полость, заполненная гноем и грануляциями. Так, в результате мастоидита возникает эмпиема сосцевидного отростка. Прорыв гноя через разрушенные стенки сосцевидного отростка приводит к распространению гнойного воспаления на соседние структуры и развитию осложнений мастоидита.
Классификация
Выделяют две клинические формы мастоидита: типичную и атипичную. Атипичная (латентная) форма отличается медленным и вялым течением без ярко выраженных характерных для мастоидита симптомов. Отдельно выделяют группу верхушечных мастоидитов, к которым относится мастоидит Бецольда, мастоидит Орлеанского и мастоидит Муре. По стадии воспалительного процесса мастоидит классифицируется как экссудативный и истинный (пролиферативно-альтеративный).

КТ височных костей. Тотальное снижение пневматизации ячеек сосцевидного отростка с обеих сторон. (фото Вишняков В.Н.)
Симптомы мастоидита
Мастоидит может появляться одновременно с возникновением гнойного среднего отита. Но чаще всего он развивается на 7-14 день от начала отита. У детей первого года жизни из-за особенности строения сосцевидного отростка мастоидит проявляется в форме отоантрита. У взрослых мастоидит манифестирует выраженным ухудшением общего состояния с подъемом температуры до фебрильных цифр, интоксикацией, головной болью, нарушением сна. Больные мастоидитом жалуются на шум и боль в ухе, ухудшение слуха, интенсивную боль за ухом, чувство пульсации в области сосцевидного отростка. Боль иррадиирует по ветвям тройничного нерва в височную и теменную область, орбиту, верхнюю челюсть. Реже при мастоидите наблюдается боль во всей половине головы.
Указанные симптомы при мастоидите обычно сопровождаются обильным гноетечением из наружного слухового прохода. Причем количество гноя заметно больше, чем объем барабанной полости, что свидетельствует о распространении гнойного процесса за пределы среднего уха. С другой стороны, гноетечение при мастоидите может не наблюдаться или быть незначительным. Это происходит при сохранении целостности барабанной перепонки, закрытии перфоративного отверстия в ней, нарушении оттока гноя из сосцевидного отростка в среднее ухо.
Объективно при мастоидите отмечается покраснение и отечность заушной области, сглаженность расположенной за ухом кожной складки, оттопыренность ушной раковины. При прорыве гноя в подкожную жировую клетчатку происходит формирование субпериостального абсцесса, сопровождающегося резкой болезненностью при прощупывании заушной области и симптомом флюктуации. Из области сосцевидного отростка гной, расслаивая мягкие ткани головы, может распространиться на затылочную, теменную, височную область. Происходящее в результате воспаления тромбирование сосудов, кровоснабжающих кортикальный слой кости сосцевидного отростка, приводит к некрозу надкостницы с прорывом гноя на поверхность кожи головы и формированием наружного свища.
Осложнения
Распространение гнойного воспаления в самом сосцевидном отростке происходит по наиболее пневматизированным ячейкам, что обуславливает разнообразие возникающих при мастоидите осложнений и их зависимость от строения сосцевидного отростка. Воспаление перисинуозной группы ячеек приводит к поражению сигмовидного синуса с развитием флебита и тромбофлебита. Гнойное разрушение перифациальных ячеек сопровождается невритом лицевого нерва, перилабиринтных — гнойным лабиринтитом. Верхушечные мастоидиты осложняются затеканием гноя в межфасциальные пространства шеи, в результате чего гноеродные микроорганизмы могут проникнуть в средостение и вызвать появление гнойного медиастинита.
Распространение процесса в полость черепа приводит к возникновению внутричерепных осложнений мастоидита (менингита, абсцесса головного мозга, энцефалита). Поражение пирамиды височной кости обуславливает развитие петрозита. Переход гнойного воспаления на скуловой отросток опасен дальнейшим заносом инфекции в глазное яблоко с возникновением эндофтальмита, панофтальмита и флегмоны глазницы. У детей, особенно младшего возраста, мастоидит может осложниться формированием заглоточного абсцесса. Кроме того, при мастоидите возможно гематогенное распространение инфекции с развитием сепсиса.
Диагностика
Как правило, диагностика мастоидита не представляет для отоларинголога никаких сложностей. Затруднения возникают в случае малосимптомной атипичной формы мастоидита. Диагностика мастоидита основывается на характерных жалобах пациента, анамнестических сведениях о перенесенной травме или воспалении среднего уха, данных осмотра и пальпации заушной области, результатах отоскопии, микроотоскопии, аудиометрии, бакпосева выделений из уха, компьютерной томографии и рентгенологического исследования.
- Отоскопия. При мастоидите выявляются типичные для среднего отита воспалительные изменения со стороны барабанной перепонки, при наличие в ней отверстия отмечается обильное гноетечение. Патогномоничным отоскопическим признаком мастоидита является нависание задне-верхней стенки слухового прохода.
- Исследование слуховой функции. Аудиометрия и исследование слуха камертоном позволяют установить степень тугоухости у пациента с мастоидитом.
- Рентгенография височной кости. В экссудативной стадии мастоидита обнаруживает завуалированные в результате воспаления ячейки и нечетко различимые перегородки между ними. Рентгенологическая картина пролиферативно-альтеративной стадии мастоидита характеризуется отсутствием ячеистой структуры сосцевидного отростка, вместо которой определяется одна или несколько больших полостей. Лучшая визуализация достигается при проведении КТ черепа в области височной кости.

Наличие осложнений мастоидита может потребовать дополнительной консультации невролога, нейрохирурга, стоматолога, офтальмолога, торакального хирурга, проведения МРТ и КТ головного мозга, офтальмоскопии и биомикроскопии глаза, рентгенографии органов грудной клетки.
Лечение мастоидита
Лечебная тактика при мастоидите зависит от его этиологии, стадии воспалительного процесса и наличия осложнений. Медикаментозная терапия мастоидита проводится антибиотиками широкого спектра действия (цефаклор, цефтибутен, цефиксим, цефуроксим, цефотаксим, цефтриаксон, амоксициллин, ципрофлоксацин и др.). Дополнительно применяют антигистаминные, противовоспалительные, детоксикационные, иммунокоррегирующие препараты. Проводят лечение осложнений.
При отогенной природе мастоидита показана санирующая операция на среднем ухе, по показаниям — общеполостная операция. Отсутствие в барабанной перепонке обеспечивающего адекватное дренирование отверстия является показанием к проведению парацентеза. Через отверстие барабанной перепонки производят промывания среднего уха лекарственными препаратами. Мастоидит в экссудативной стадии может быть излечен консервативным путем. Мастоидит пролиферативно-альтеративной стадии требует хирургического вскрытия сосцевидного отростка (мастоидотомии) для ликвидации гноя и послеоперационного дренирования.
Профилактика мастоидита
Предупреждение отогенного мастоидита сводится к своевременной диагностике воспалительного поражения среднего уха, адекватному лечению отитов, своевременному проведению парацентеза барабанной перепонки и санирующих операций. Корректная терапия заболеваний носоглотки и быстрая ликвидация инфекционных очагов также способствуют профилактике мастоидита. Кроме того, имеет значение повышение работоспособности иммунных механизмов организма, что достигается ведением здорового образа жизни, правильным питанием, при необходимости — иммунокоррегирующей терапией.
Мастоидит – воспаление слизистой оболочки, которая выстилает пещеру и ячеистые структуры сосцевидного отростка височной кости. Он расположен позади уха и состоит из костных полостей, заполненных воздухом. Заболевание чаще всего вторичное, и является осложнением среднего отита. Первичный мастоидит развивается преимущественно после травмы. При отсутствии лечения в патологический процесс могут быть вовлечены соседние структуры, в том числе и головной мозг, что приводит к серьезным осложнениям.
Причины возникновения мастоидита

Причина заболевания – бактерии (пневмококк, золотистый стафилококк, β-гемолитический стрептококк, гемофильная палочка и пр.), которые попали в ячейки сосцевидного отростка. Есть три пути проникновения патогенных микроорганизмов:
- Отогенный. Бактерии попадают в сосцевидный отросток из барабанной полости среднего уха.
- Гематогенный. Микроорганизмы заносятся с током крови. Такое бывает при туберкулезе, вторичном сифилисе или сепсисе.
- Травматический. При черепно-мозговой травме, огнестрельном ранении развивается первичный мастоидит.
Развитию заболевания способствует ряд факторов:
- высокая вирулентность бактерий;
- ослабленная хроническими заболеваниями иммунная система;
- заболевания ЛОР-органов;
- органические изменения в структуре уха, возникшие в результате перенесенной травмы или заболевания.
Патогенез
После внедрения патогенной микрофлоры в слизистой начинаются воспалительные изменения. Она отекает и закрывает все отверстия между ячейками, а также проход, которым сообщаются сосцевидный отросток и барабанная полость. Вентиляция нарушается, давление воздуха в ячейках падает. Их заполняет экссудат, сначала серозный, потом серозно-гнойный.
На второй стадии гнойный процесс распространяется на костную ткань, провоцируя остеомиелит. Перегородки между ячейками разрушаются. В результате образуется одна большая полость с гноем и грануляционной тканью. Из-за деструкции стенок сосцевидного отростка возможен прорыв гноя и распространение воспаления на окружающие структуры с развитием серьезных осложнений.
Формы и симптомы заболевания

Чаще всего патология появляется в течение 1-2 недель после заболевания средним отитом. Общее состояние резко ухудшается, температура повышается, появляются головная боль и нарушения сна. Развивается интоксикация организма.
Пациентов беспокоят снижение слуха, шум в ухе и болезненные ощущения, ииррадиирующие по ветвям тройничного нерва в висок или теменную область. Кроме того, они отмечают пульсацию и боль в проекции сосцевидного отростка. Эти симптомы часто сопровождаются интенсивным гноетечением из уха.
При осмотре можно заметить гиперемию кожи и припухлость за ухом. Ушная раковина немного оттопырена. При прорыве гноя формируется субпериостальный абсцесс, характеризующийся резкой болью за ухом и флюктуацией внутри припухлости.
Осложнения
Осложнения при мастоидите очень разнообразны и напрямую зависят от строения сосцевидного отростка, в частности от того, какая именно группа ячеек была разрушена. Возможно развитие неврита лицевого нерва, флебитов, тромбофлебитов, гнойного лабиринтита. Если очаг воспаления находится в верхушке сосцевидного отростка, гной затекает в межфасциальное пространство шеи, а оттуда патогенные микроорганизмы проникают в средостение и вызывают медиастинит.
Распространение гнойного воспаления в полость черепа провоцирует появление менингита, энцефалита, абсцесса головного мозга. В зависимости от того, какая структура будет вовлечена, возможно развитие петрозита, панофтальмита, эндофтальмита, флегмоны глазницы. При попадании бактерий в кровь развивается сепсис.
Методы диагностики
Диагностика типичной формы заболевания не составляет затруднений. Она основана на жалобах, анамнезе, клинической картине, данных осмотра и пальпации заушной области. В специфическое обследование пациента входят:
- Отоскопия и микроотоскопия. Можно увидеть воспалительные изменения в барабанной перепонке, возникающие при среднем отите. Из отверстия в ней вытекает гной. Заметно нависание задне-верхней стенки слухового прохода.
- Аудиометрия и исследование слуха камертоном. Позволяют определить степень тугоухости при мастоидите. . Делают посев материала на уточнение типа возбудителя и его чувствительность к антибиотикам.
- КТ черепа. Исследуют область височной кости на предмет осложнений.
- Рентгенография височной кости. В экссудативной стадии на снимке еще видны ячейки и нечеткие перегородки между ними. В пролиферативно-альтеративной стадии вместо них можно обнаружить несколько больших полостей, заполненных гноем.
При подозрениях на осложнения понадобятся консультации профильных специалистов – невролога, нейрохирурга, офтальмолога, стоматолога, торакального хирурга. Они могут провести дополнительное обследование пациента – МРТ или КТ головного мозга, офтальмоскопию, биомикроскопию глаза, рентген органов грудной клетки.
Лечение мастоидита
Медикаментозную терапию проводят при первой, экссудативной стадии заболевания. При ней назначают:
- антибиотики широкого спектра действия;
- антигистаминные;
- противовоспалительные;
- препараты для дезинтоксикации;
- иммунокорректоры.
Во второй стадии заболевания показано хирургическое лечение. Если мастоидит образовался на фоне среднего отита, проводят санирующую операцию и промывание среднего уха лекарственными препаратами. Отсутствие в барабанной перепонке отверстия является показанием к парацентезу. С целью дренирования и создания оттока гноя из сосцевидного отростка проводят мастоидотомию.
Профилактика мастоидита заключается в своевременной диагностике и лечении воспаления среднего уха, а также санации очагов хронической инфекции и укреплении иммунитета.
Читайте также:
